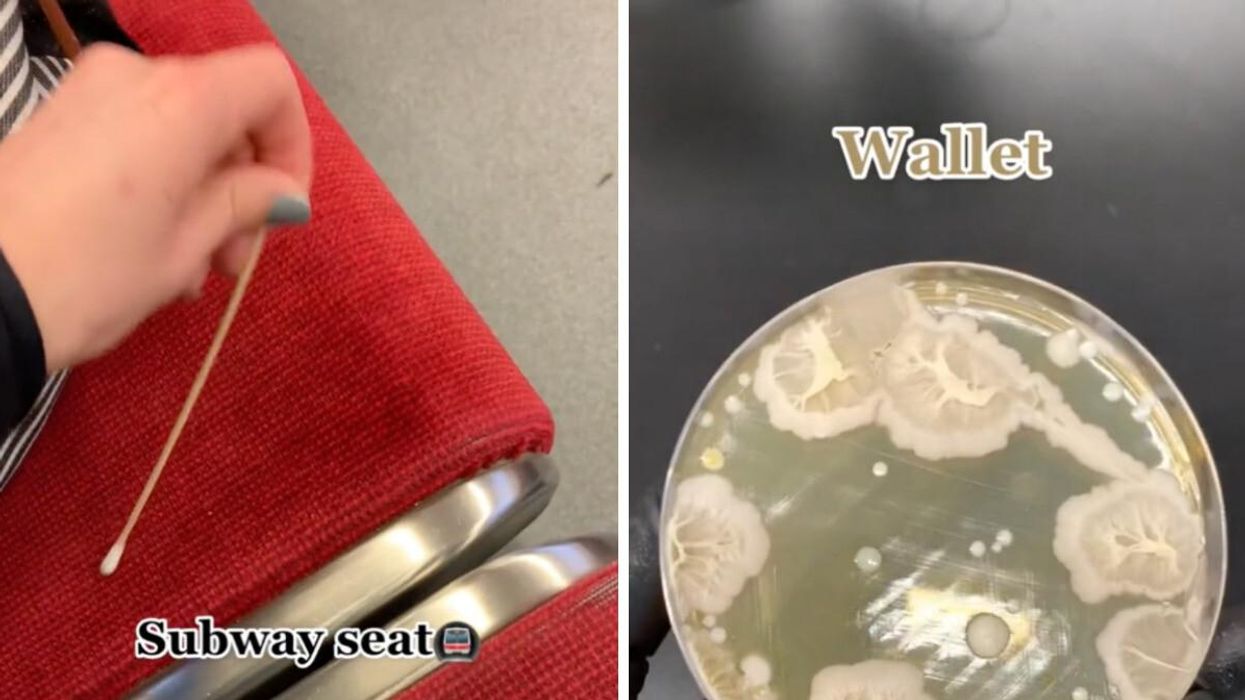

This Viral TikTok Shows How Much Bacteria Is On A TTC Seat vs. A Water Fountain & It's Shocking
It's definitely not what you'd expect.
CM taking a swab sample of a TTC subway seat. Right: Bacteria from a wallet.
Do you ever wonder what kind of organisms live on a TTC subway seat? Well, a Toronto TikToker might have the answer for you.
A TikToker, who goes by CM and was a "germophobe" in her past life, is a Master of Science student who shares videos for fun and to make herself feel less scared.
One of the videos she shared has over 9 million views and gained a lot of attention because the results shown are not what someone in Toronto would expect.
The video shows how much bacteria actually live on things around her, and it's super fascinating.
@the_lab_life1 The subway seat is the only thing giving me hope #fyp #foryoupage #lab #science
CM took swabs from a TTC subway seat, her boss's wallet and a water fountain and put them onto a "nutrient agar plate which supports bacterial growth," she told Narcity.
The scientist then put the plates into an incubator at a specific temperature, usually around 37 C, where it sat for 24-48 hours before being taken out for observation, CM added.
In the video that went viral on TikTok, the experiment results show that CM's boss's wallet was the one that cultivated the most bacteria, followed by the water fountain and finally the TTC subway seat — shocking, isn't it?
@the_lab_life1 Don’t come for my wired headphones, I like them ! #fyp #foryoupage #lab #science
It's worth noting that "the bacteria that ultimately grows on the plate cannot be completely associated with cleanliness," CM said.
She explains that "all humans have a diverse array of microorganisms living within them and on their skin which is part of the normal human microbiota. The microbiota is essential for our overall health and wellbeing."
The bacteria that lies on the skin is not harmful. However, when swabbing something else, there is a possibility that harmful bacteria, such as E.Coli, can grow. But, it is only worrisome when they are seen in large amounts.
"Therefore, we should regard it as, 'are these bacteria possibly harmful vs is this dirty?'" she said.
"Everything will always have some sort of microbiome on it, but I have learned to accept that. It's like the bacteria have their own little lives and cities, but instead it's on an apple," the scientist added.
Even though her results show that the wallet held the most bacteria, CM said she can't truly compare results because "certain bacteria need a specific temperature, pH or nutrient to grow, so you can never truly capture all the bacteria living on a surface using one generic test."
So, don't worry about using the water fountain. CM reassured us that she'll still use the fountain even after seeing some funky-looking bacteria.
- TikTok's Text-To-Speech Girl Is Actually From Ontario & People Can't Believe She's Real ›
- Toronto Police Arrest 14-Year-Old Boy In Viral TikTok Taxi Scam & Are Warning The Public ›
- A Tim Hortons Employee In Ontario Is Going Viral On TikTok & The Video Explains It All ›
- TTC Employee Goes 'Rogue' On A Train Speaker & Urges People To Contact John Tory's Office - Narcity ›
- A TikToker Swabbed Sephora Makeup Testers For Bacteria & You Probably Won't Want To Use Them - Narcity ›
- These TTC Bus Routes Just Got A Major Upgrade & Here's How It Will Affect Your Commute - Narcity ›
- The TTC Is Closing A Bunch Of Toronto Subway Stations For The Next 2 Weekends & Here's Where - Narcity ›
- Toronto's 'Slowest' TTC Bus Routes Were Revealed & Upgrades Are Coming — Eventually - Narcity ›